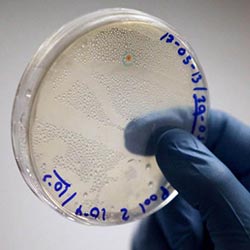

REPORTE UNA NOTICIA
Si tiene una noticia, contáctenos
noticias@petrolnews.net
Si tiene una noticia, contáctenos
noticias@petrolnews.net
Copyright 2019 © Petrolnews.net - Todos los derechos reservados
Petrolnews es editado en la Ciudad de Neuquén y en la Ciudad Autónoma
de Buenos Aires, RepĂşblica Argentina
Teléfono (54 11) 4774 2154
Petrolnews es editado en la Ciudad de Neuquén y en la Ciudad Autónoma
de Buenos Aires, RepĂşblica Argentina
Teléfono (54 11) 4774 2154
PUBLICIDAD
Si quiere contratar publicidad contáctenos
publicidad@petrolnews.net
Si quiere contratar publicidad contáctenos
publicidad@petrolnews.net

 - BRENT 100,33
- BRENT 100,33  | DIVISAS: DOLAR 1.395,00 - EURO: 1.650,00 - REAL: 28.300,00 | MINERALES: ORO 4.777,24 - PLATA: 75,89 - COBRE: 574,27
| DIVISAS: DOLAR 1.395,00 - EURO: 1.650,00 - REAL: 28.300,00 | MINERALES: ORO 4.777,24 - PLATA: 75,89 - COBRE: 574,27